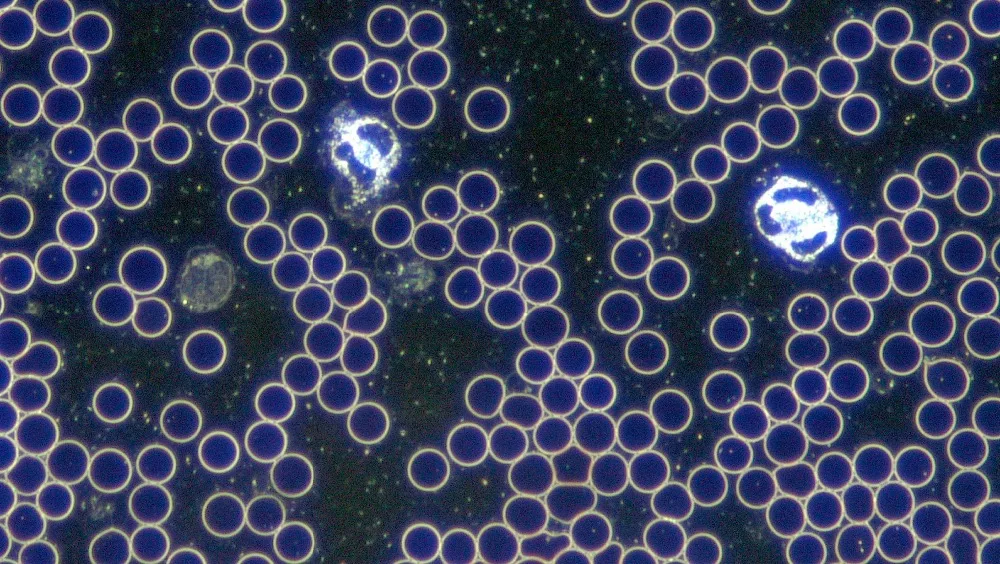
thumb

Scientific Microscope Darkfield Objective 100X/1.25 160/0.17 Oil Plan Darkfield Objective with Iris Diaphragm-RMS4/5''X1/36''

sku: 32859944449
ACCORDING TO OUR RECORDS THIS PRODUCT IS NOT AVAILABLE NOW
$215.99
Shipping from: China
Technical Details
| Application: | Darkfield microscope with195mm optical system |
| Brand Name: | ISOLAB |
| Certificate: | CE ,ISO |
| Color: | Silver |
| Magnification: | Plan Darkfield Objective 100x with Iris- Oil |
| Model Number: | 195mm-100x-Darkfield -Plan -2018 |
| Mounting Screw Thread: | 4/5''X1/36'' RMS screw |
| N.A: | NA 1.25mm-0.5 adjustable |
| Parfocal: | 45mm |
| Quality: | Top quality for German, Japan , USA high market |
| Wholesaling OEM Service: | Yes |
| Working Distance: | 0.13mm |
Price history chart & currency exchange rate
Customers also viewed

$13.06
Brushed Gold Hand Held Bathroom Head Shower Gold Finished Brass or Spray Handheld Bath Shower Stainless Heads Steel Shower Rain
aliexpress.com
$21.68
Customized Ferris wheel photo frame, self installed, 6-24 5-inch photos on both sides, birthday, Valentine's Day, Christmas gift
aliexpress.com
$24.95
Мышь A4Tech Fstyler FB45CS Air серый оптическая (2000dpi) silent беспроводная BT/Radio USB (7but)
allsoft.ru
$5.20
Vivid Workshop DATA 2018.01v Parts Catalog Automotive Atris -Technik Vivid Europe Repair Software Vivid 2018 2015 V10.2 Garage
aliexpress.com
$51.34
Колокольчик с колокольчиком, 20 баров, музыкальный инструмент, деревянная рамка, Ударные музыкальные игрушки, колокольчик с колокольчиком, музыкальный инструмент, колокольчик с колокольчиком
aliexpress.ru
$28.31
LR129166 Tie Rod End Ball Joint Steering Outer For Land Rover Defender 110 90 Front Lower Control Arm Ball Head
aliexpress.com
$57.98
4 pcs Set Suit Rim Wheel Cover For Renault Clio Megane Fluence 15 inch Rubber Cover Accessories Free Shipping Auto wheel covers
aliexpress.com
$32.34
Hi-Spec 3/6/12Pcs Chisel Set Punch Tool Chisel Sharpener Center Punch Woodworking And Accessories Wood Punching Tools With Bag
aliexpress.com
$15.10
2022 Winter Coat Men Casual Zippers Winter Fashion Thickened Cotton Coat Pockets Stand Loose Men Clothing Winter Jackets
aliexpress.com
$23.54
Thickened Women's Pajamas Robe Kawaii Clothes Coral Velvet Hooded Nightgown Warm Bathrobe Loungewear for Women Winter Sleep Wear
aliexpress.com
$6.51
1Roll 2M Baby Safety Edge Guard Strip Soft Desk Table Security L/M-Shaped Kids Protection Angle Home Anti-collision
aliexpress.com
$3.42
good a++ car metal keychain men 's leather creative keychain activity small gift customizable logo kr044 keychains mix order 20 pieces, Slivery;golden
dhgate.com
$7.99
Fashion Men Summer T Shirt Set 3D Prined Short Sleeve Tshirt Shorts Overszied Clothes Casual Streetwear Tracksuit Men Sport Suit
aliexpress.ru
$16.58
CHILDREN'S School Bags GIRL'S And BOY'S 6-12-Year-Old Waterproof Light 1-6 Grade Young STUDENT'S Backpack
aliexpress.com
$1,712.77
Customizable Good Quality Cost Effective 50cc Scooter Street Gas Powered Motor Moped
aliexpress.com
$9.30
Настольные украшения, вечный календарь ручной работы, индивидуальный вращающийся календарь «сделай сам», дисплей месяца, портативный настольный календарь, офисный
aliexpress.ru













